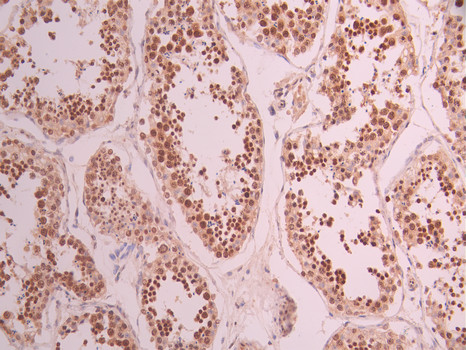

HMGB2 Recombinant Monoclonal Antibody
-
中文名稱:HMGB2 Recombinant Monoclonal Antibody
-
貨號:CSB-RA230291A0HU
-
規格:¥1320
-
圖片:
-
Western Blot
Positive WB detected in: HL-60 whole cell lysate(30μg), Jurkat whole cell lysate(30μg), COLO-205 whole cell lysate(30μg), HEK293 whole cell lysate(30μg), THP-1 whole cell lysate(30μg)
All lanes: HMGB2 antibody at 1:1000
Secondary
Goat polyclonal to rabbit IgG at 1/40000 dilution
Predicted band size: 24 kDa
Observed band size: 28 kDa
Exposure time:2min -
IHC image of CSB-RA230291A0HU diluted at 1:100 and staining in paraffin-embedded human lung cancer performed on a Leica BondTM system. After dewaxing and hydration, antigen retrieval was mediated by high pressure in a citrate buffer (pH 6.0). Section was blocked with 10% normal goat serum 30min at RT. Then primary antibody (1% BSA) was incubated at 4°C overnight. The primary is detected by a Goat anti-rabbit polymer IgG labeled by HRP and visualized using 0.05% DAB.
-
IHC image of CSB-RA230291A0HU diluted at 1:100 and staining in paraffin-embedded human testis tissue performed on a Leica BondTM system. After dewaxing and hydration, antigen retrieval was mediated by high pressure in a citrate buffer (pH 6.0). Section was blocked with 10% normal goat serum 30min at RT. Then primary antibody (1% BSA) was incubated at 4°C overnight. The primary is detected by a Goat anti-rabbit polymer IgG labeled by HRP and visualized using 0.05% DAB.
-
Immunofluorescence staining of SH-SY5Y cell with CSB-RA230291A0HU at 1:50, counter-stained with DAPI. The cells were fixed in 4% formaldehyde, permeabilized using 0.2% Triton X-100 and blocked in 10% normal Goat Serum. The cells were then incubated with the antibody overnight at 4°C. The secondary antibody was Alexa Fluor 488-congugated AffiniPure Goat Anti-Rabbit IgG(H+L).
-
Overlay Peak curve showing jurkat cells stained with CSB-RA230291A0HU (red line) at 1:100. The cells were fixed in 4% formaldehyde and permeated by 0.2% TritonX-100 for 10min. Then 10% normal goat serum to block non-specific protein-protein interactions followed by the antibody (1ug/1*106cells) for 45min at 4℃. The secondary antibody used was FITC-conjugated goat anti-rabbit IgG (H+L) at 1/200 dilution for 35min at 4℃.Control antibody (green line) was Rabbit IgG (1ug/1*106cells) used under the same conditions. Acquisition of >10,000 events was performed.
-
-
其他:
產品詳情
-
Uniprot No.:
-
基因名:HMGB2
-
別名:High mobility group protein B2 (High mobility group protein 2) (HMG-2), HMGB2, HMG2
-
反應種屬:Human
-
免疫原:A synthesized peptide from human HMGB2 protein
-
免疫原種屬:Homo sapiens (Human)
-
標記方式:Non-conjugated
-
克隆類型:Monoclonal
-
抗體亞型:Rabbit IgG
-
純化方式:Affinity-chromatography
-
克隆號:11B2
-
濃度:It differs from different batches. Please contact us to confirm it.
-
保存緩沖液:Preservative: 0.03% Proclin 300
Constituents: 50% Glycerol, 0.01M PBS, PH 7.4 -
產品提供形式:Liquid
-
應用范圍:ELISA, WB, IHC, IF, FC
-
推薦稀釋比:
Application Recommended Dilution WB 1:500-1:2000 IHC 1:50-1:200 IF 1:50-1:200 FC 1:50-1:200 -
Protocols:
-
儲存條件:Upon receipt, store at -20°C or -80°C. Avoid repeated freeze.
-
貨期:Basically, we can dispatch the products out in 1-3 working days after receiving your orders. Delivery time maybe differs from different purchasing way or location, please kindly consult your local distributors for specific delivery time.
-
用途:For Research Use Only. Not for use in diagnostic or therapeutic procedures.
相關產品
靶點詳情
-
功能:Multifunctional protein with various roles in different cellular compartments. May act in a redox sensitive manner. In the nucleus is an abundant chromatin-associated non-histone protein involved in transcription, chromatin remodeling and V(D)J recombination and probably other processes. Binds DNA with a preference to non-canonical DNA structures such as single-stranded DNA. Can bent DNA and enhance DNA flexibility by looping thus providing a mechanism to promote activities on various gene promoters by enhancing transcription factor binding and/or bringing distant regulatory sequences into close proximity. Involved in V(D)J recombination by acting as a cofactor of the RAG complex: acts by stimulating cleavage and RAG protein binding at the 23 bp spacer of conserved recombination signal sequences (RSS). Proposed to be involved in the innate immune response to nucleic acids by acting as a promiscuous immunogenic DNA/RNA sensor which cooperates with subsequent discriminative sensing by specific pattern recognition receptors. In the extracellular compartment acts as a chemokine. Promotes proliferation and migration of endothelial cells implicating AGER/RAGE. Has antimicrobial activity in gastrointestinal epithelial tissues. Involved in inflammatory response to antigenic stimulus coupled with proinflammatory activity. Involved in modulation of neurogenesis probably by regulation of neural stem proliferation. Involved in articular cartilage surface maintenance implicating LEF1 and the Wnt/beta-catenin pathway.
-
基因功能參考文獻:
- HMBG2 overexpression promotes ischemia/reperfusion-induced cell apoptosis through activating the JNK1/2-NF-kappaBp65 signaling in AC16 cardiomyocytes. PMID: 30119172
- Authors demonstrate that HMGB2 transcription is repressed by p21 during radiation-induced senescence through the ATM-p53-p21 DNA damage signaling cascade. The loss of p21 abolished the downregulation of HMGB2 caused by ionizing radiation, and the conditional induction of p21 was sufficient to repress the transcription of HMGB2. PMID: 29487276
- identified the oncogene HMGB2 as a downstream target of miR-130a by using luciferase and western blot assays. Knockdown of HMGB2 mimicked the effect of miR-130a in glioma cells. PMID: 28851665
- Serum HMGB2 levels were associated with in-stent restenosis in patients. PMID: 28183701
- results establish HMGB2 as a novel master regulator that orchestrates senescence-associated secretory phenotype. PMID: 27799366
- Data indicate the function of high mobility group box 2 (HMGB2) in glycolytic control in pancreatic cancer. PMID: 28069585
- data demonstrate a reciprocal relationship between Hmgb2 and Ctcf in controlling aspects of chromatin structure and gene expression. PMID: 27226577
- Lrp1-antisense directly binds to high-mobility group box 2 (Hmgb2) and inhibits the activity of Hmgb2 to enhance Srebp1a-dependent transcription of Lrp1. PMID: 25937287
- Data show that odulation of RNA helicase DDX18 directly affects growth of tamoxifen-resistant cells, suggesting that it may be a critical downstream effector of the estrogen receptors (ERs) and high mobility group box 2 (HMGB2) complex. PMID: 25284587
- siRNA-mediated silencing of HMGB2 increased the sensitivity of the head and neck squamous cell carcinoma cell lines to cisplatin and 5-fluorouracil. PMID: 25327479
- The present data suggest that HMGB2 expression is a significant prognostic factor for glioblastoma and might play an important role in cell invasion. PMID: 23828241
- HMGB2 is necessary to protect colorectal cancer cells from DNA damage and efficient DNA repair and p53-mediated downregulation is a critical mechanism of modulating HMGB2 expression. PMID: 23255232
- Transient local HMGB2-DNA contacts dominate the DNA-bending mechanism used by HMGB proteins to increase DNA flexibility. PMID: 23143110
- The age-related loss of HMGB2 in articular cartilage may represent a mechanism responsible for the decline in adult cartilage stem cell populations. PMID: 21890638
- The results can partly be explained by altered cell proliferations by HMGB2 associated with the antiapoptotic pathway. PMID: 20851854
- Our findings collectively suggest that HMGB2 could stabilize p53 by interfering with E6/E6AP-mediated p53 degradation in HPV-positive HeLa cells. PMID: 20036050
- HMGB2 potentiates GATA-1-dependent transcription of GFI1B by Oct-1 and thereby controls erythroid differentiation. PMID: 19965638
- HMG2 interacts with the nucleosome assembly protein SET and is a target of the cytotoxic T-lymphocyte protease granzyme A. PMID: 11909973
- binds specifically to the first AT-rich region flanking the hypersensitive site 2 core sequence of the human beta-globin gene locus control region PMID: 12555809
- biophysical analysis of HMG domain from human HMGB2 binding to DNA PMID: 15833996
- HMG2 was determined in humans. PMID: 17406091
- single and double box proteins increase DNA flexibility and stability, albeit both effects are achieved at much lower protein concentrations for the double box. PMID: 17964600
- In human and murine cartilage, there is an aging-related loss of HMGB2 expression, ultimately leading to its complete absence. PMID: 19139395
- An isolated HMG box A domain from human HMGB2 does not enhance DNA flexibility. Substitution of a small number of cationic residues from the N-terminal leader of a functional yeast box B protein, Nhp6Ap, confers the ability to enhance DNA flexibility. PMID: 19236006
顯示更多
收起更多
-
亞細胞定位:Nucleus. Chromosome. Cytoplasm. Secreted.
-
蛋白家族:HMGB family
-
組織特異性:Expressed in gastric and intestinal tissues (at protein level).
-
數據庫鏈接:
Most popular with customers
-
-
YWHAB Recombinant Monoclonal Antibody
Applications: ELISA, WB, IHC, IF, FC
Species Reactivity: Human, Mouse, Rat
-
Phospho-YAP1 (S127) Recombinant Monoclonal Antibody
Applications: ELISA, WB, IHC
Species Reactivity: Human
-
-
-
-
-